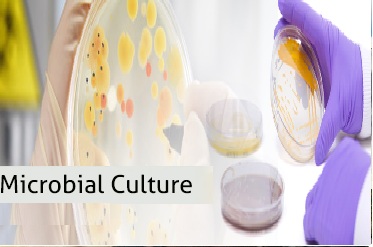

It is highly effective liquid antiscalant/antifoulant developed to control scale precipitates and reduce particulate fouling within membrane separation systems. Use of this product provides longer run times and extended element life resulting in reduced operating and capital costs. Use in industrial applications show excellent results in membrane separation processes including Reverse osmosis (RO), nanofiltration (NF) and ultrafiltration (UF) applications.
FEATURES OF RO ANTISCALANT/ANTIFOULANT :
- Effective scale inhibition and low chemical dosage
- High recovery rate and cost effective
- Excellent results as a replacement for softener filters
- Effective over a wide pH range

Boiler water treatment products incorporate oxygen scavengers, and alkalinity boosters for corrosion inhibition, and anti-scalants to prevent concrete-style scale build-up in boilers. Addition of boiler chemicals minimizes or even eliminates corrosion and scaling inside a boiler and significantly prolongs its lifetime. This is the simplest and most cost-effective way to protect your investment in a boiler system. Our full line of boiler chemicals is designed to keep your system free from scale and corrosion, giving you more time to focus on what matters most.
FEATURES OF BOILER CHEMICALS :
- Prepare feedwater before it goes to the boiler
- Protect and keep the internal boiler surfaces clean
- Maximize condensate return

We are offering Iron Removal Media of superior performance with reasonable prices. To remove Iron from water you need to install an Iron Water Filter which will help remove iron from your water, Iron in the water leads to red staining in appliances and clothing and in toilet bowls.
APPLICATIONS :
- Useful for removing iron from the water
- Widely used in Water Treatment applications
- Used for filtration of oil and lubricants

Our Advanced Cooling Solution is an innovative offering that can help you control and maintain your cooling systems with greater efficiency, reliability. It lowers your total cost of ownership and minimizes the environmental impact of your operation.

We are a leading organization in offering Fire Retardant Chemical to our clients. It is used for protection of material from effects of fire.
FEATURES OF FIRE RETARDANT CHEMICALS :
- Accurate formulation
- Fine quality
- Longer life
We are a recognized name and involved in offering an unmatched range of Composting MIcrobes. ACURO's microbial culture is a wonderful microbial product to resolve complex problems of sewage and solid waste treatment. Our multi-pronged sewage treatment solution refines the sewage and frees it from solid impurities to make it fit for industrial use thereby saving water required for composting. For sewage treatment, we use both anaerobic and aerobic methods.
FEATURES OF MICROBIAL CULTURE :

WATER FILTER MEDIA Delivering the Highest Quality Industrial Minerals and Water Filtration Media . MECBURG Filter media products are the highest quality media delivers the finest water filtration and well pack media in the world. Our wide range of filter media like: water filter sand, silex, gravel and pebbles etc, the exacting standards set for drinking water and pool water filtration media.
FEATURES OF WATER FILTER MEDIA :
- RO ANTISCALANTS
- POLYELECTROLYTES
- ACTIVATED CARBON
- RO MAINTENANCE CHEMICALS
- IRON REMOVAL MEDIA
- WATER FILTER MEDIA
- CHLORINE TABLETS
- ION EXCHANGE RESINS
- MICROBIAL CULTURE
- COOLING TOWER CHEMICALS
- BOILER CHEMICALS
- PERACETIC ACID
- SILVER HYDROGEN PEROXIDE
- SWIMMING POOL CHEMICALS
- BIOCIDES & DISINFECTANTS
- HOSPITAL DISINFECTANTS
- SUPER ABSORBENT POLYMERS
- SPECIALITY CHEMICALS
- AGRICULTURE CHEMICALS
- PAPER CHEMICALS
- FIRE RETARDANT CHEMICALS
- DEFOAMER
- BULK CHEMICALS
- HOUSEKEEPING CHEMICALS